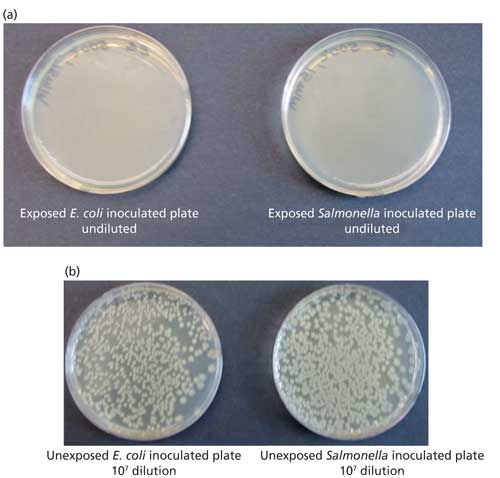

Gas Chromatography–Mass Spectrometry Characterization of Vegetable Oil–Derived Potent Antimicrobial Agents
Special Issues
Under a suitable thermal oxidation regime, vegetable oils yield a mixture of volatile and semivolatile organics that exhibit very high antimicrobial activities against a variety of microbial species. Volatile and semivolatile products were characterized with GC–MS using electron ionization and chemical ionization. The thermal oxidation of vegetable oils resulted in the formation of an array of short and medium-chain acids, aldehydes, and ketones that act synergistically to yield a potent antimicrobial disinfectant.
Under a suitable thermal oxidation regime, vegetable oils yield a mixture of volatile and semivolatile organics that exhibit very high antimicrobial activities against a variety of microbial species. Volatile and semivolatile products were characterized with gas chromatography–mass spectrometry (GC–MS) equipped with electron ionization (EI) and chemical ionization (CI) sources. The GC–MS results showed that the antimicrobial mixture comprised short and medium chain organic acids, aldehydes, and ketones, including propanal, butanal, hexanal, octanal, nonanal, propionic acid, hexanoic acid, heptanoic acid, and octanoic acid. Microbial exposure experiments showed that a short exposure period of less than 2 min was effective in killing vegetative bacterial cells with efficiencies as high as 109. The present report deals primarily with chemical characterization of the volatile and semivolatile organics with GC–MS.
Rising concerns for resistance of microbial species to specific antibiotics have aroused interest in nonspecific broad-spectrum disinfectants (1). Selected plant species have been noted for possessing antimicrobial activities since prehistoric times, and renewed interest has been generated toward plant-based antimicrobial agents. Considerable attention is being paid to plant-derived oils and extracts as broad-spectrum disinfectants. Essential oils obtained through hydrodistillation of basil plants (Ocimum basilicum) were found to contain terpene alcohols (linalool) and exhibited strong antifungal activity (2). Antibacterial and antifungal activity of eucalyptus wood (Eucalytus glubulus) extracts have also been reported and noted the presence of gallic acid, ellagic acid, and citric acid (3).
Similarly, the generation and use of oil-derived disinfectants was described in ancient times-for example, the ancient Indian text “Vedas” describes purification rituals that involve offering clarified butter (ghee) to the fire god Agni. The text states that the offering does not destroy the components, but transforms constituents into minuscule constituents that can purify the environment by the elimination of harmful organisms (4,5). However, the chemicals produced or the chemical transformation of oils during the ritual has not been described in open literature. Chemical transformation of vegetable oils during storage at ambient temperatures and during food preparation has been studied and reviewed extensively (6–11). The emphasis of such studies have been on the production of off-flavor compounds, such as aldehydes, and the generation of trans fatty acids. Although the production of aldehydes and ketones from the autooxidation of polyunsaturated fats and oils has been known for some time, the antimicrobial activity of such oxidation products derived from biogenic oils has not been reported in the literature.
Oil-based obscurant generation involves a process that is somewhat similar to the ancient Vedic rituals and involves volatilization of oils at high temperatures. Under ambient temperatures vapors condense to form aerosols-droplets with diameters ranging from 0.5 to 2 μm. Such droplets when present in high concentrations are very effective in scattering visible and near-infrared (NIR) radiation, forming a “fog” or obscurant medium (12,13). During laboratory simulation experiments to assess the mutagenicity of the aerosols it was discovered that when aerosols or vapors are generated under suitable oxidation regimes, an extremely potent antimicrobial mixture is formed. Experiments carried out to date have shown that the process permits generation of a highly effective wide-spectrum microbicidal–sporicidal chemical vapor from nontoxic oils. The process involves controlled pyrolytic oxidation of a relatively innocuous substance such as hydrocarbon based mineral oils, or preferably natural esters (vegetable oils or their monoesters), leading to the generation of a mixture of antimicrobial agents including volatile organic acids, aldehydes and ketones. The mixture has exhibited exceptional antimicrobial activity.
A study was initiated to quantify disinfectant efficiency of the oil-derived vapors against a variety of pathogenic microbial species including Gram-positive and -negative bacteria, bacterial spores, fungal spores, and viruses. Tandem experiments were carried out to characterize major volatile and semivolatile constituents of the oil-derived disinfectant vapors. Characterization was carried out with a tandem gas chromatography–mass spectrometry (GC–MS) system. The results showed that under suitable conditions thermal oxidation of vegetable oils resulted in the formation of short and medium chain acids, aldehydes, and ketones that act synergistically to yield a very potent microbial disinfectant.
Experimental
Volatilization and Transformation Oils
The bench-top setup for volatilization of oils consisted of a 40 cm x 1.25 cm (o.d.) stainless steel tube. The tube was placed in an electrically heated tubular furnace. The temperature of the furnace was controlled with a feedback type temperature control unit; temperature of the reactor was monitored and controlled with a feedback circuit. Oils were introduced into the stainless steel tube with a reciprocating piston pump at flow rates of 0.25 or 0.5 mL/min. Gas (air or argon) flow through the tube was controlled with a mass flow controller and varied between 2 and 10 L/min. The volatilization temperature was varied from 350 °C to 600 °C (±5 °C). Oil and gas were introduced in to the reactor tube through a concentric tube arrangement. A simple schematic of the setup is shown in Figure 1. The split stream setup of the generation system allowed simultaneous execution of microbial toxicity assay and chemical characterization of volatile organics.
Figure 1: A schematic of the bench-scale vapor generation, exposure, and gas sampling setup.

Figure 2: Comparison of bacterial cultures (a) exposed to soybean oil-derived disinfectant vapors and (b) diluted unexposed cultures.
Soybean oil used during the experiment was purchased locally and methyl soyate was purchased from AG Environmental Products L.L.C. Other vegetable oils used during the experiments included linseed oil, olive oil, and corn oil, which were all obtained locally. Fog oil was obtained from the U.S. Army Chemical School. Fog oil is a middle distillate of petroleum similar to the commercially available mineral oil. It is used for the generation of smoke (osbcurant) screens through vaporization and condensation processes.
Microbial Tests
The bacterial species were precultured in 5 mL of nutrient broth without shaking at room temperature for 12 h. The absorbance of the preculture was observed at 560 nm. The preculture was used when the absorbance readings reached between 0.6 and 0.8. A 150-µL aliquot of the preculture was diluted with 850 µL of nutrient broth. Two 10-µL drops of the diluted preculture were added to a nutrient agar plate. For the toxicity assay, the nutrient agar plates were exposed to vapors for 2, 5, or 10 min in the exposure chamber. The plate was incubated at 37 °C for 24 h and examined for the presence of bacterial colonies.
Chemical Characterization of Volatiles and Semivolatiles with GC–MS
The chemical characterization of vapors was carried out with a GC–MS system consisting of a Varian 3800 gas chromatograph interfaced to a Varian 920 mass spectrometer. Characterization of volatile components was facilitated with a cryotrap and a six-port sampling valve (model C6W, Valco Instruments). An aliquot of the vapor stream was transferred from the gas sampling bulb into the GC column with the six-port valve. The valve was mounted inside the column oven and maintained at the oven temperature. A fused-silica tube with a volume of 50 μL served as the sampling loop. During the sampling mode, the gas sample was pulled through the loop with a low-volume vacuum pump at a flow rate of 30 mL/min. At the end of the sampling period, the valve was switched to transfer the sample into the GC column.
GC Parameters
The following GC parameters were used:
Column: 60 m x 0.25 mm (i.d.) fused-silica capillary with a 95% methyl, 5% phenyl polysiloxane stationary phase
Carrier: Helium, ultrahigh purity grade, volume flow rate 1 mL/min
Linear velocity: 28 cm/s
Injection: On-line loop, with a loop volume of 50 μL
Cryogen: CO2
Cryotrap cycle: Cryogen, switched on 1.50 min before injection, switched off 2.50 min after injection
Oven temperature: -10 °C initial, 3-min hold, then 8 °C/min to a final temperature of 200 °C, hold 4 min
MS Parameters
The MS system comprised a triple-quadrupole analyzer with an electron ionization (EI) and chemical ionization (CI) source. The ion source could be operated in the EI or CI modes. In the EI mode, the electron energy was set at 60 eV. Methane was used as the reagent gas in the CI mode. The mass spectrometer was operated in the scan mode over a range of 40–450 amu. The scan speed was set at 0.5 s.
Results and Discussion
Microbial Exposure Results
The efficacy of the oil-derived vapor in controlling vegetative bacterial cell growth was assessed by examining agar plates inoculated with several bacterial strains including Escherichia coli and Salmonella typhimurium. Undiluted bacterial cultures were applied to nutrient agar plates and exposed to the oil-derived vapors. The agar plates inoculated with diluted bacterial culture were used as the controls and the dilution factor was ten million or one hundred million fold, that is, 1×107 or 1×108. All exposures were carried out at ambient temperature for time periods of 2–15 min for the vegetative bacterial cultures and up to 1 h for the bacterial and fungal spores. Exposed and control plates were incubated at 37 °C for 24 h. The plates were examined for colonies on the exposed and control plates. A quantitative measure of disinfectant efficiency was made on the basis of the number of colonies on the exposed plates with undiluted cultures and unexposed plates with diluted bacterial cultures.
Disinfection efficiency = [number of colonies on the exposed plate x dilution / number of colonies on the control (unexposed) plates x dilution/]
For example, the number of colonies on the unexposed plates inoculated with diluted (1x108) Salmonella typhimurium culture was found to be 66. There were no colonies observed on the exposed plate with undiluted culture when exposed to vapors generated through volatilization of soybean oil at 550 °C. The disinfection efficiency for Salmonella typhimurium after exposure to soybean oil-derived vapors was estimated to be 66 x 108 or 6.6 x 109 fold, or better than nine logs. Similar results were obtained with Escherichia coli, unexposed plates with 1x108 diluted culture showed an average count of 82 colonies. Whereas not even a single colony was observed on plates exposed to vapors generated from soybean oil, the disinfectant efficiency in this case was calculated to be 82x108 or 8.2x109, more than nine logs.
Similar results were obtained with other bacterial species, including Mycobacterium smegmatis, Mycobacterium phlei, Salmonella typhimurium, Klebsiella pneumonia, Escherichia coli, Pseudomonas aeruginosa, Enterobacter cloacae, Shigella sonnei, Serratia marcescens, Bacillus subtilis, Bacillus stearothermophilus, Staphylococcus aureus, Staphylococcus epedermis, and Streptococcus mutans. The antimicrobial strength of the vapors was found to depend on the starting oil, volatilization temperature, and gas present during volatilization. Microbial exposure experiments showed that antimicrobial activity depends on the chemical composition of volatile and semivolatiles present in the vapor stream.
Chemical Characterization of Disinfectant Vapors
GC Separation of Volatile Components
Volatile and semivolatile constituents of disinfectant vapors were separated with GC. Separations were carried out with the 60-m fused-silica capillary with a relatively nonpolar stationary phase. To facilitate separation of volatile components, the initial temperature of the GC column oven was set at -10 °C. This initial temperature was selected by monitoring the separation of model analytes such as acetaldehyde, acetone, isopropanol, butanal, butanone, and hexanal. The subambient initial column temperatures minimized the band broadening of volatile analytes and yielded narrower peaks, resulting in superior resolution.
Qualitative and Quantitative Determination of Volatile Components
The qualitative determination of volatile components was carried out using MS with the ion source in EI mode. CI was used for positive confirmation of labile analytes that do not yield molecular ion at satisfactory abundance in the EI mode. The identity of some of the analytes was confirmed through collision induced dissociation (CID) of a pseudomolecular ion obtained with CI. Quantification of all compounds detected in the vapor stream was carried out with the internal standard method. Ion intensities for standard analytes were obtained at four different concentrations over the 1–100 µg/L range. Deuterated benzene (C6D6) was used as the internal standard.
Total ion chromatograms (TICs) of “particulate free” gas stream with volatile and semivolatile organics formed during volatilization of soybean oil at 400 °C and 550 °C are shown in Figures 3a and 3b, respectively. Chromatograms show that oil volatilized at 550 °C yielded a higher number of volatile and semivolatile products than volatilization at 400 °C. Identification of the product peaks, where possible, was established through retention time match with known standard and EI mass spectra match when such matches were found in the library. In cases where the identity could not be established with reasonable certainty, CI spectra were used to enhance the certainty of identification. This approach was found to be useful in confirming the identity of short chain alkyl aldehydes and other analytes that did not yield an abundant molecular ion in the EI.
Figure 3: TICs of volatile organics in vapors streams from soybean oil volatilized at(a) 400 °C and (b) 550 °C.

TICs obtained in the EI and CI mode showed essentially the same retention times and reasonable similarity in relative abundances of peaks. The EI and CI spectra of a dominant peak (marked with an asterisk *) in the TIC of soybean oil volatilized at 400 °C and 550 °C are shown in Figures 3a and 3b, respectively. The EI spectrum of the peak showed a very weak ion at m/z 100 and with fragment ions at m/z 44, 56, 72, and 82. The ion at 44 results from the classical γ hydrogen rearrangement followed by radical site initiated α cleavage as depicted in Figure 4a.
Figure 4: Fragmentation of (a) hexanal molecular ion in the EI spectrum, (b) hexanal pseudomolecular ion in the CI spectrum, (c) 2-heptanone molecular ion in the EI spectrum, and (d) 2-heptanone following γH rearrangement in EI spectrum.

The CI spectrum of the same peak showed three predominant ions at m/z 83, 101, and 201, the pseudomolecular (M+H)+ ion appeared at m/z 101, as shown in Figure 5b. The CI spectrum contain strong pseudomolecular ions and a strong fragment ion resulting from the loss of water as a neutral molecule, through γ hydrogen rearrangement followed by inductive cleavage and loss of water as a neutral species (Figure 4b). The ion at m/z 201 in the CI spectrum is most likely the adduct ion [(M+H)+M]+ and the presence of this ion indicates that the analyte is present at high concentration, is indeed n-hexanal.
Figure 5: Mass spectra of a predominant peak in the TIC of soybean oil volatilized at 400 °C: (a) EI, (b) CI.

The EI and CI spectra of another strong peak in the TIC of soybean oil volatilized at 550 °C are shown in Figures 6a and 6b, respectively. The base ion in the EI spectrum was at ion m/z 41, the highest mass ion was observed at m/z 98. Other ions were observed at m/z 55, 69, and 83. The CI spectrum of the peak showed a single ion at m/z 99, the protonated pseudomolecular (M+H)+. The peak is most likely that of 2-heptenal. Other peaks in the chromatogram were identified through this approach were found to be short and medium chain aldehydes and acids, including hexanal, heptanal, octanal, nonanal, hexanal, 2-hexenal, heptenal, propionic acid, hexanoic acid, heptanoic acid, and nonanoic acid.
Figure 6: Mass spectra of another strong peak in the TIC of soybean oil volatilized at 550 °C: (a) EI, (b) CI.

The TICs of vapors formed during volatilization of mineral oil (fog oil, FO) under the same conditions used for soybean oil are shown in Figures 7a and 7b, respectively. Fog oil is a middle distillate petroleum product and it comprises a large number of branched chained hydrocarbons that are difficult to resolve, and chromatograms of such oils show a “hump.” The hump is evident in both chromatograms. The chromatogram of oil volatilized at 550 °C showed higher numbers of volatile species (Figure 7b). The chromatogram of oil volatilized at 400 °C contained fewer volatiles. The identities of volatile and semivolatile compounds in the vapor stream was carried out through an analogous approach used in the case of volatiles generated with soybean oil.
Figure 7: TICs of volatile organics in vapor streams from fog oil volatilized at 400 °C and (b) 550 °C.

The vapor stream resulting from volatilization of fog oil over the 400–550 °C temperature range was found to contain higher concentrations of ketones and alkenes. The EI spectra of the most predominant peak in the TIC of fog oil volatilized at 400 °C showed the presence of a weak ion at m/z 114, possibly the molecular ion and strong fragment ions at m/z 43 and 58 (Figure 8a). Such ions are characteristic of ketones-for example, the ion at m/z 43 most likely resulted from α-cleavage (Figure 5c) whereas the ion at m/z 58 resulted from γ-H rearrangement followed by α-cleavage (Figure 5d). The CI spectrum of the same peak showed a dominant ion at 115, most likely the pseudomolecular ion (M+H)+. An adduct ion peak was also observed at m/z 229, most likely (M+H+M)+ (Figure 8b). Thus, strong evidence for the presence of heptanone was provided.
Figure 8: Mass spectra of a predominant peak in the TIC of fog oil: (a) EI, (b) CI.

The volatized fog oil stream also contained alkenes. The identities of analytes were quantified through internal standard normalized ion intensities obtained with the EI source. The predominant volatile and semivolatile compounds detected in the fog oil vapor streams were acetone, 2-pentanone, 2-hexanone, hexane, heptane, 2-heptanone, decane decene, and undecane. The fog oil stream contained lower concentrations of aldehydes and acids.
Comparisons of oxygenated molecules concentration and total volatiles obtained with different oils showed that concentrations of volatiles and antimicrobial activity were affected by two parameters: the composition of the starting material and the volatilization temperature. The results showed that volatilization temperature had a marked effect on the type and amount of total volatile components. Quantitative chemical characterization showed that production of the volatile species increased with an increase in temperature as long as the temperature was less than the combustion temperature; relative concentrations of volatile products obtained from fog oil and soybean oil over the volatilization temperature range is shown in Figure 9. The formation of volatile and semivolatile organics from other vegetable oils and monoesters showed a similar trend. Results showed that the composition of volatile and semivolatile organics produced during volatilization of oils is dependent on the chemical composition of oils, volatilization temperature, and volatilization atmosphere. The composition had a direct bearing on antimicrobial activity of the vapor stream. The antimicrobial activity of soybean oil and fog oil streams on vegetative E. coli are summarized in Table I.
Figure 9: Aggregated concentration of volatile and semivolatile organics in the vapor stream of soybean oil and fog oil volatilized at different temperatures.


Short- and medium-chain aldehydes and acids produced during volatilization of vegetable oil, such as soybean oil, act as highly effective antimicrobial agents and seem to support the assumptions made in ancient literature.
Conclusions
GC–MS characterization of volatile and semivolatile chemicals produced during rapid volatilization of oils at elevated temperatures results in the formation of an array of short- and medium-chain oxygenated molecules, including ketones, aldehydes, and acids. The formation depends on the oil being volatilized, the volatilization temperature, and the atmosphere. Higher yields are obtained from vegetable oils with a higher degree of unsaturation, such as the soybean oil. Yields are lower from petroleum oils such as mineral oil.
Oxygenated molecules, especially aldehydes and acids, act synergistically and show potent antimicrobial activities against a very wide variety of microbes including vegetative bacteria , bacterial spores, and fungal spores.
References
- World Health Organization, Fact Sheet Antimicrobial Resistance (AMR) (WHO, updated September 2016).
- D. Beatovic, D.K. Milosevic, S. Trifuovic, J. Siljegovic, J. Glamoclija, M. Ristic, and S. Jelacic, Rec. Nat. Prod.9(1), 62–75 (2015).
- A. Lius, D.M. Neiva, H. Pereira, J. Gominho, F. Domingues, and A.P. Duarte, Ind. Crops Prod.91, 97–103 (2016).
- Rigveda 1.72.3 (2000–1500 BCE).
- Atharvaveda 1.8.1 (1500–1000 BCE).
- E. Choe and D.B. Min, Compr. Rev. Food Sci. Food Saf. 5(4), 169–186 (2006).
- C.H. Gertz, Eur. J. Lipid Sci. Technol. 102, 543–551 (2000).
- A.K. Rani, S.Y. Reddy, and R. Chetana, Eur. Food Res. Technol. 230(6), 803–811 (2010).
- J. Kamsiah and Y. Kamisah, in Lipid Peroxidation, A. Catala, Ed. (InTech Open, 2012), pp. 211–228.
- V.S. Rubalya, P. Neelanegam, and S.R. Vignesh, Int. J. ChemTech Res.6(11), 4671–4677 (2014).
- A.M. Ashaful, H.H. Majuki, M.A. Abul Kalam, R. Ashrafur, M. Habibullah, and M. Syazwan, Energy and Fuels28(2), 1081–1089 (2014).
- K.S. Snelson, R. Butler, R. Farlow, R. Welker, and S. Mainer, “Physical and Chemical Characterization of Military Smokes” Fog oils and oil fogs InstituteDAMD17-787-8085. ADA093205. IIT Research Institute, Chicago, IL. (US Army Technical Report, 1980).
- K. Stackleberg, C. Amos, T. Smith, D. Cropek, and B. MacAllister, “Military Smokes and Obscurants - Fate and Effects,” ERDC/CERL TR-04-29, (US Army Technical Report, 2004) US Army Corps of Engineers.
Racha Seemamahannop and Shubhen Kapila are with the Department of Chemistry at Missouri University of Science and Technology in Rolla, Missouri. Prakash Wadhawa is with the Department of Chemical Engineering at Missouri University of Science and Technology. Abha Malhotra is with the History Department at Himachal University in Shimla, Himachal Pradesh, India. Direct correspondence to: kapilas@mst.edu

Next Generation Peak Fitting for Separations
December 11th 2024Separation scientists frequently encounter critical pairs that are difficult to separate in a complex mixture. To save time and expensive solvents, an effective alternative to conventional screening protocols or mathematical peak width reduction is called iterative curve fitting.
Investigating the Influence of Packaging on the Volatile Profile of Oats
December 10th 2024In the testing of six different oat brands, headspace sorptive extraction and comprehensive two-dimensional gas chromatography time-of-flight mass spectrometry (GC×GC–TOF-MS) reveal how various packaging types can affect and alter the oats’ volatile profile, underscoring the potential impact of packaging on food quality.
The Chromatographic Society 2025 Martin and Jubilee Award Winners
December 6th 2024The Chromatographic Society (ChromSoc) has announced the winners of the Martin Medal and the Silver Jubilee Medal for 2025. Professor Bogusław Buszewski of Nicolaus Copernicus University in Torun, Poland, has been awarded the prestigious Martin Medal, and the 2025 Silver Jubilee Medal has been awarded to Elia Psillakis of the Technical University of Crete in Greece.